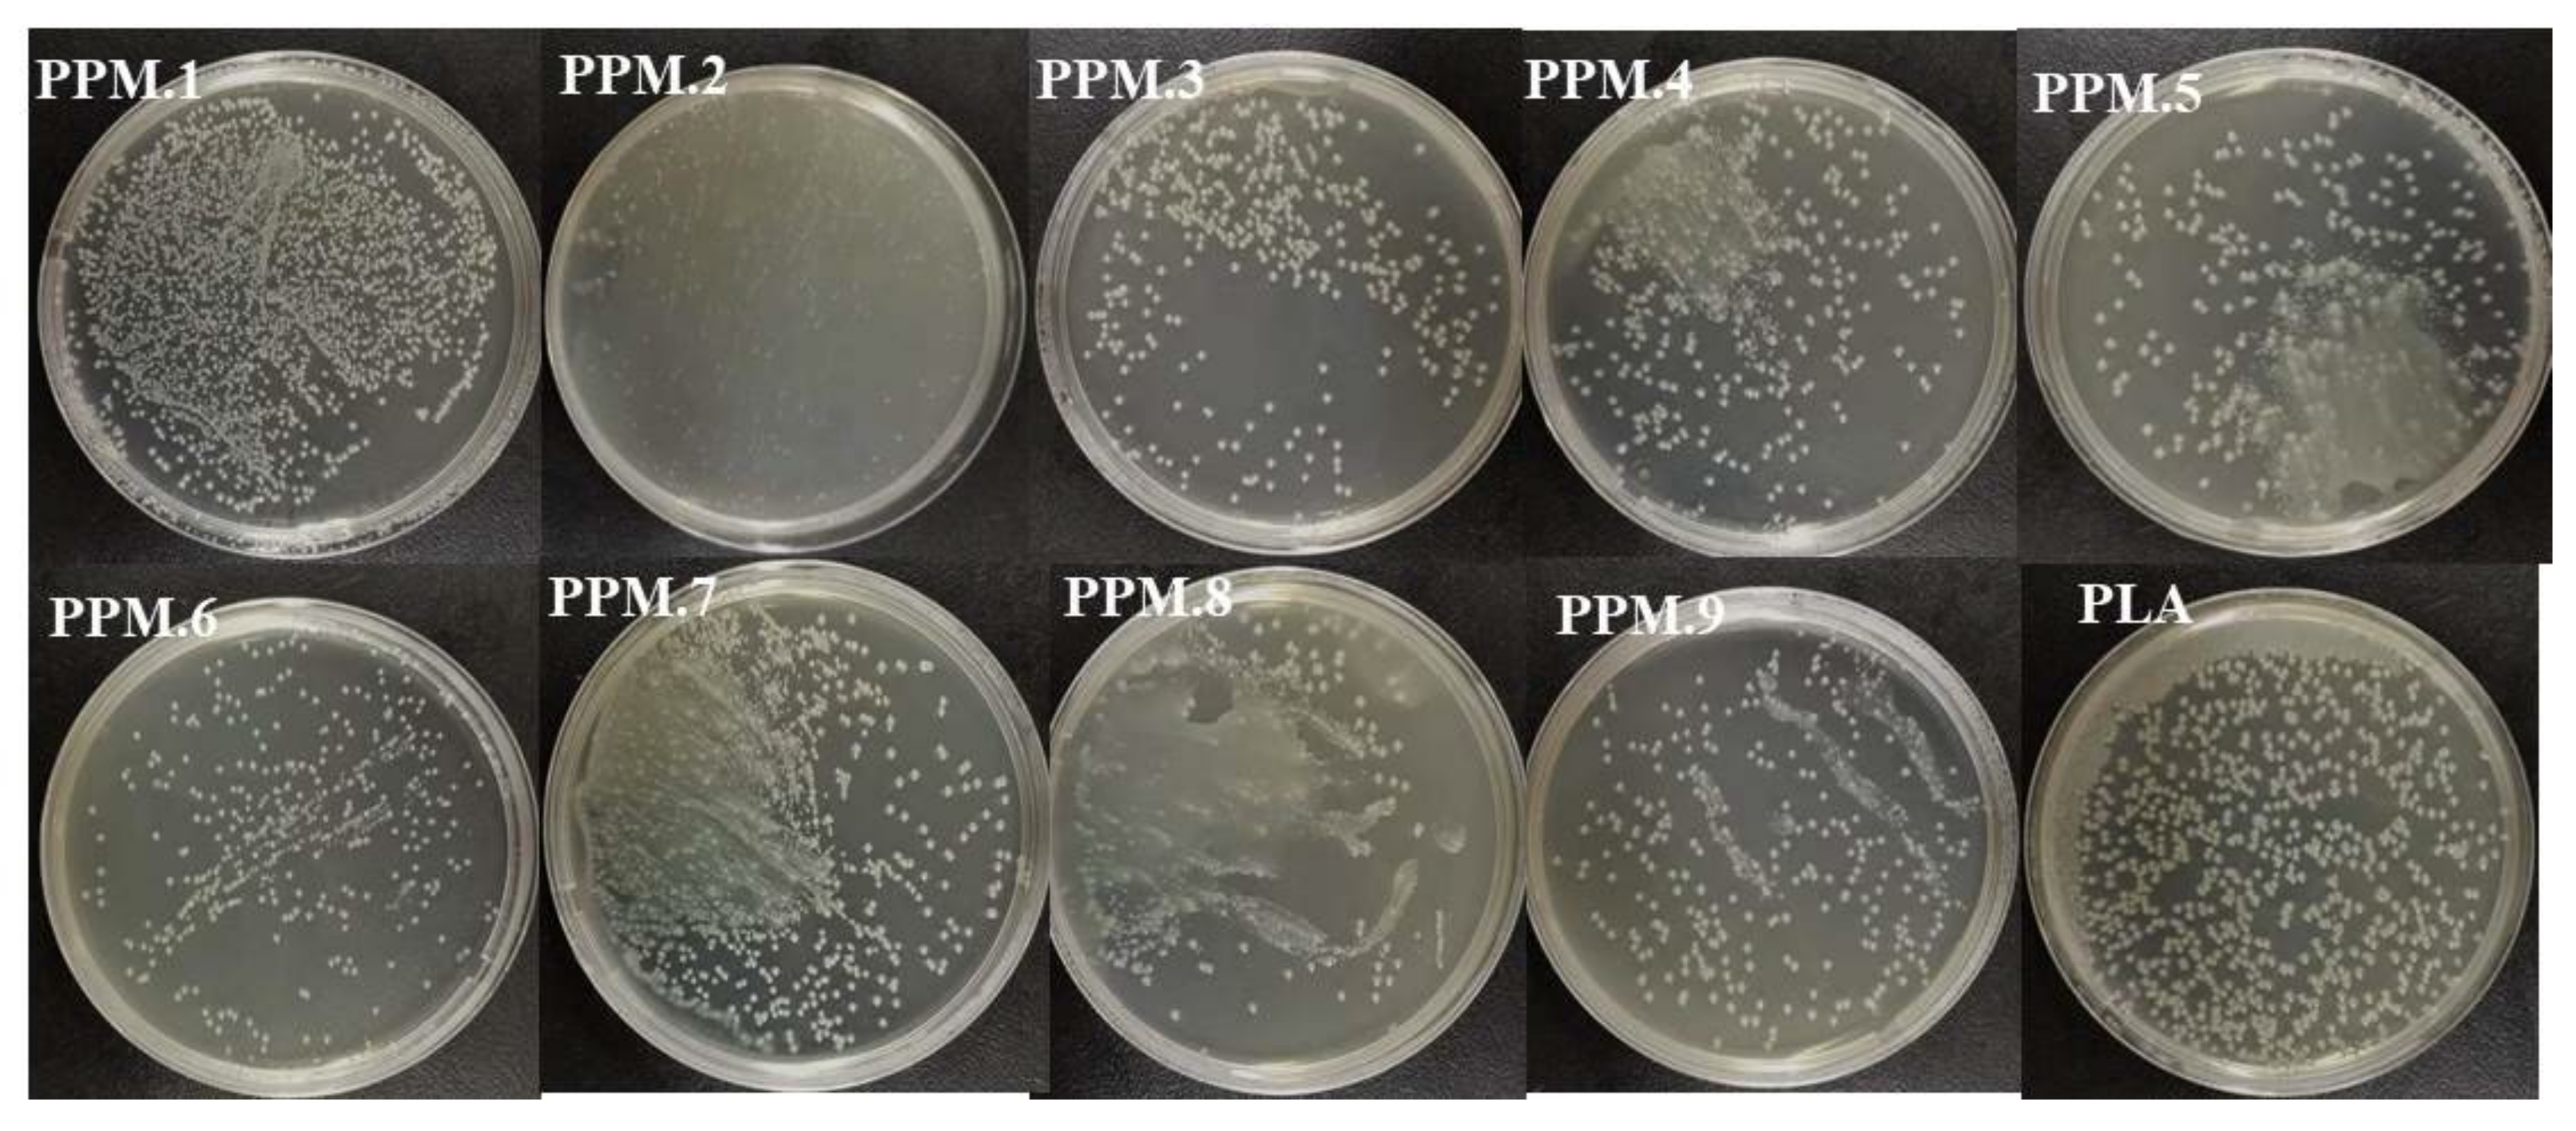
Nanomaterials 12 02932 g007 550

Correction: Xie et al. Preparation and Characterization of New Electrospun Poly(Lactic Acid) Nanofiber Antioxidative Active Packaging Films Containing MCM-41 Mesoporous Molecular Sieve Loaded with Phloridzin and Their Application in Strawberry Packaging. Nanomaterials 2022, 12, 1229
Error in Figure

Reference
- Xie, Y.; Cheng, G.; Wu, Z.; Shi, S.; Zhao, J.; Jiang, L.; Jiang, D.; Yuan, M.; Wang, Y.; Yuan, M. Preparation and Characterization of New Electrospun Poly(lactic acid) Nanofiber Antioxidative Active Packaging Films Containing MCM-41 Mesoporous Molecular Sieve Loaded with Phloridzin and Their Application in Strawberry Packaging. Nanomaterials 2022, 12, 1229. [Google Scholar] [CrossRef] [PubMed]
Publisher’s Note: MDPI stays neutral with regard to jurisdictional claims in published maps and institutional affiliations. |
© 2022 by the authors. Licensee MDPI, Basel, Switzerland. This article is an open access article distributed under the terms and conditions of the Creative Commons Attribution (CC BY) license (https://creativecommons.org/licenses/by/4.0/).
Share and Cite
Xie, Y.; Cheng, G.; Wu, Z.; Shi, S.; Zhao, J.; Jiang, L.; Jiang, D.; Yuan, M.; Wang, Y.; Yuan, M. Correction: Xie et al. Preparation and Characterization of New Electrospun Poly(Lactic Acid) Nanofiber Antioxidative Active Packaging Films Containing MCM-41 Mesoporous Molecular Sieve Loaded with Phloridzin and Their Application in Strawberry Packaging. Nanomaterials 2022, 12, 1229. Nanomaterials 2022, 12, 2932. https://doi.org/10.3390/nano12172932
Xie Y, Cheng G, Wu Z, Shi S, Zhao J, Jiang L, Jiang D, Yuan M, Wang Y, Yuan M. Correction: Xie et al. Preparation and Characterization of New Electrospun Poly(Lactic Acid) Nanofiber Antioxidative Active Packaging Films Containing MCM-41 Mesoporous Molecular Sieve Loaded with Phloridzin and Their Application in Strawberry Packaging. Nanomaterials 2022, 12, 1229. Nanomaterials. 2022; 12(17):2932. https://doi.org/10.3390/nano12172932
Chicago/Turabian StyleXie, Yuan, Guiguang Cheng, Zhoushan Wu, Shang Shi, Jinghao Zhao, Lin Jiang, Dengbang Jiang, Mingwei Yuan, Yudan Wang, and Minglong Yuan. 2022. "Correction: Xie et al. Preparation and Characterization of New Electrospun Poly(Lactic Acid) Nanofiber Antioxidative Active Packaging Films Containing MCM-41 Mesoporous Molecular Sieve Loaded with Phloridzin and Their Application in Strawberry Packaging. Nanomaterials 2022, 12, 1229" Nanomaterials 12, no. 17: 2932. https://doi.org/10.3390/nano12172932
APA StyleXie, Y., Cheng, G., Wu, Z., Shi, S., Zhao, J., Jiang, L., Jiang, D., Yuan, M., Wang, Y., & Yuan, M. (2022). Correction: Xie et al. Preparation and Characterization of New Electrospun Poly(Lactic Acid) Nanofiber Antioxidative Active Packaging Films Containing MCM-41 Mesoporous Molecular Sieve Loaded with Phloridzin and Their Application in Strawberry Packaging. Nanomaterials 2022, 12, 1229. Nanomaterials, 12(17), 2932. https://doi.org/10.3390/nano12172932

